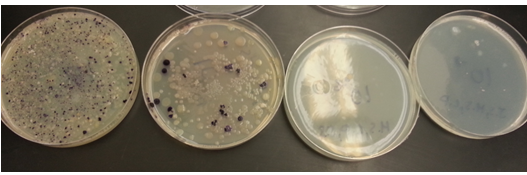

User:Ji Won Shin/Notebook/Biology 210 at AU
March 22,2014: Understanding Embryology by Means of Zebrafish (1)Introduction: A control group and a treatment group can be made to contrast the effect of the treatment ot the control. Zebrafish were exposed to flouride and its affects were observed to understand embryoic development and factors that affect it. I predict that the flouride would affect zebrafish development so that their development is slowere than the control zebrafish.
(2)Purpose: to determine effect of flouride on Zebrafish development.
(3)Materials and Method: 1. Read Reference text on Flouride and its effects on embryonic development to gain prior knowledege. 2. Set up two petri dishes, one labled control and other Flouride. 3. Fill each petri dish with 20 mL of its respetive liquid: control with water and flouride with 10mg/L flouride solution 4. Fill each petri dish with at least 20 zebrafish eggs. 5. Observe the eggs every other day, replacing 10 mL of the old liquid with new liquid to prevent evaporation. 6. Fix three samples of zebrfish by placing in .02% tricaine solution which would be placed in 4% formalehyde for preservation.
(4)Data and Observation:
Table 1: Zebrafish Observations
Note: On Day 2, one fish from control and two from flouride were sacrificed and preserved.
(5)Conclusion: Overall, the zebrafish of the flouride solution showed slow or incomplete growth compared to the ones in the control group. Although they did hatch faster than the control group, their development was slower. Also, they tended to die more easily than the control groups. From this, it can be concluded that zebrafish have slwoer development when exposed to flouride, proving the prediction from before to be true. Based on this, the end result can be assumed to have happened because of the speed of development. Due to the weather, the zebrafish hatched faster than normal and ran out of food because of this fast development and died. The flouride zebrafish, however, had stunted growth and therefore was able to last longer because they had their yolks for a longer period of time than the control group, giving them more days of nutrients. For future stuides, the effects of flouride based on amount and on different stages of growth would be an interesting direction. Whether the amount of flouride show different results and insertion of flouride in differnt stages of growth show different effects would show differnt results would be observed.
JS
March 16,2014: DNA Sequencing
(1)Introduction: DNA sequencing can be used to identify bacterial gene of a specific transect. To understand DNA sequencing, two samples (M3-T1-2,S1-T1-12) from transect 1, the mini marsh, were chosen and their genetic sequences were generated. Using a online database, the sequences were identified in order to recognize the possible organism most likely to match the sequence. Based on the characteristic of the transect, bacteria identified will most likely to be ones that live in wet habitats.
(2)Purpose: to identify bacterial gene from DNA sequencing done in Lab 3 and to identify organism most likely to match genetic sequence.
(3)Materials and Method
PCR: 1. Two bacterial samples from two different agar plates of the transect(nutrient agar and nutrient-tetracycline agar) chosen. 2. Each sample transferred to sterile tube filled with 100 µL of water. 3. Samples incubated at 100°C for 10 minutes and then centrifuged. 4. After centrifuge, 5 µL of supernatant formed by centrifuge used for PCR reaction in agarose gel 5. Results shown best out of PCR reaction sent to Genewiz inc.
Identification: 1. DNA sequence of transect, given by TA ran through NCBI Blast 2. Most likely bacteria chosen
Note: In case that results of PCR did not show, a different lab section's DNA sequence were used to identify the likely organisms of the transect.
(4)Data and Observations
(5)Conclusion: True to the prediction, the types of bacteria found, Psuedomonas and Chryseobacterium, are both bacteria found in wet areas. Because a different sample result than intended were used, it can not be for certain, but it is most likely that these two bacteria are the bacterial samples obtained in lab. Only the genus were identified for these samples, but these serve as a point in identifying bacteria of transect 1 because the transect matches the description of the habitats of the bacteria.
JS February 26,2014: Understanding Invertebrates and their Significance in the Environment (1)Introduction: Structures of invertebrates can show evolution over time. Depending on the organism, the difference between their systems can be seen, some thing simple and some being complex. This difference shows how organisms have evoleved thorough time and how it affects their movement and living style. A Berlese Funnel can be used to look at some of these invertebrates by waking them from their dormant state. In turn, vertebrates of a transect can be seen how they interact with these invertebrates and overall see the food web that would be constructed from interactions seen.
(2)Purpose: to understand structures of invertebrates and their importance and how they show the evolution of simple systems to complex systems.
(3)Materials and Methods:
- The examples of Acoelomates, Pseudocoelomates, and Coelomates (Planaria, nematodes, and the Annelida repsectively) were observed with a dissecting microscope, noting the movements of each organisms and how their structures affect their movment. - Invertebrates collected from the Berlese Funnel were observed with a dissecing microscope after the funnel was borken down. Main Groups for the invertebrates were deduced and the invertebrates themselves were identified. When organisms from the Berlese Funnel were identified, West Virginia samples were also seen and identified and sorted to what kind of organism it was. - Looking at the transect, the type of vertebrates that might live in the transect was determined, forming a food web based on the biotic/abiotic charactrisitics of the niche and the classification of the organisms.
(4)Data and Observations:
Note: Because the images were seen thorough a dissecting microscope and not a compound microscope, there were no rulers to measure the organism as it was seen.
(5)Conclusion:
From looking at the differnt worms, it can be seen that the structure of the worms affect their movement. Acoelomates have the most range of movement, having no body cavity at all while coelomates have a more patterned movement. Their different structures account for all their differences. Looking at the invertebrates from the transect, there were two found: the bee and the flea. Out of the invertebrates seen thorough the microscope, in terms of length, the centipede was the longest but in terms of width, the true bug was the largest. It could not be determined which invertebrate was most common becasue only two were found in my transect. As it can be seen from figure 1, every thing is connected to each other, whether an organism is being eaten or eating another. For example, the sparrowhawk would eat a chipmunk, which eats plants/flowers, which when decomposed creates bacteria. All things end up dead in the end no matter their hierarchy in the food system, all coming to one point. For the next time that this lab is performed, it would be useful to have more samples because my transect, the mini marsh, lacked invertebrates that I could look at, which made it difficult to see what would be most common.
JS
February 25,2014: Understanding the Characteristics that Differentiate Plants and the Importance of Fungi
(1)Introduction:The difference between plants would be analyzed and noted by looking at samples from the transect, including vascularization, reproduction, and other function of plants. Fungi will also be analyzed to better understand its structure and importance in nature. A Berlese Funnel will be constructed for the next lab in order to collect invertebrates. I predict that not much invertebrates will be found in the next lab because of the nature of the transect; invertebrates would have been washed out because of the draining purpose of the transect.
(2)Purpose: to understand the characteristics of plants and the diversity of plants that come from the different characteristics by using a microscope as a tool to observe plant structures. Also to understand the function and importance of a fungi in the environment. To observe DNA sequence result and note what occurred.
(3)Materials and Methods:
Identification of Plants - 5 plant samples from the transect were collected, as well as the seeds or other reproductive parts of plants. Each sample was analyzed and their characteristics were written in the lab notebook. Characteristics as overall shape, size, and vascularization was written. Plant specialization was observed by looking at the stomata as well as other cells of a plant leaf under the microscope. Reproductive parts of a plant were also analyzed by looking at different types of plants and their different reproductive mechanisms.
Fungi: - An Agar plate with fungal organism was looked at with a dissecting microscope. The fungi was drawn and recorded in the notebook, along with a reason as to why it is a fungus.
Berlese Funnel: - Berlese Funnel constructed in order to collect invertebrates for next lab.
1. About 25 mL of 50:50 ratio of ethanol and water solution poured into bottle. 2. Screening material placed inside bottom of funnel to block leaf litter from falling into solution. 3. Funnel placed into neck of bottle, which was placed in styrofoam. 4. Leaf litter sample placed in funnel. 5. Lighted 40 watt lamp placed above funnel with bulb placed about 1-2 inches above leaf litter. 6. Everything covered in foil and left for a week.
(4)Data and Observations:
Figure 1:
- Samples 1,2, and 5 showed vascularization common to dicot plants (figure 3 for vascular system of dicot); Net pattern of veins on leaves were observed. - Sample 3 and 4 showed vascularization of monocot plant (figure 3 for vascular system of monocot); leaves of monocot plants parallel and vertical.
- fungal organism observed with microscope. Appearance similar to black bread mold seen in lab manual. Black sporangia can be seen, as well as white threadlike mycelium.
(5)Conclusion:
True to the prediction of the last lab, the DNA sequence for last lab's sample did not show up, as seen in Figure 4 (2nd from the left). As such, the sample from the last lab was not to be used for the future lab. For this lab, the prediction in the introduction cannot be determined false until the next lab. In this lab, it was determined that the samples 1,2,5 were dicotyledons and that sample 3 and 4 were monocotyledons. As such, both samples displayed characteristics specialized to plants of that category.
Because the plant samples were collected during cold weather, evidence of reproductive structures were unable to be observed, the assumption being that flowering structures of the samples would have been observed in warm weather.
The fungal organism observed under the microscope was deemed to be black bread mold because of its similar appearance to the one shown in the lab manual. The black sporangia and white threadlike mycelium shown confirmed this conclusion. The sporangia of fungi are important because they are structures that contain and produce spores. Fungi are able to reproduce because of sporangia. The spores from the sporangia spread and create fungi. For the next lab, invertebrates of the transect would be observed, using the berlese funnel to wake them.
JS
February 16,2014: Identification of Bacteria through Gram Stains
(1)Introduction: The characteristics of bacteria will be assessed by gram staining samples from different agar plates. Since there were two types of agar plates, one with tetracycline and one without, the two different plates will be observed to compare and contrast the difference in bacteria growth. The same samples used in the gram staining will also be used to prepare PCR for the next lab's DNA sequencing. I predict that for the next lab's DNA sequencing, my PCR would not show a proper DNA sequence.
(2)Purpose: to understand the characteristics of bacteria using Gram Staining as a tool and observe their resistance to bacteria by the difference shown in separate agar plates. Also to understand DNA sequencing as a tool of identification by preparing PCR.
(3)Materials and Methods:
Observation of Agar Plates:
-Serial Dilutions done on agar plates last lab were seen. The colony size on each plate was counted and plates with too many colonies to count were considered a lawn. Differences between the nutrient agar plates with and without agar plates were recorded, along with what this might indicate. The effect of tetracycline was observed and colonies per mL of the culture was also observed.
- 3 samples were collected from the plates, 2 from the nutrient agar plate and 1 from the nutrient agar plate with tetracycline, an antibiotic. The three sample colonies were recorded for their elevation, color, form, and margin. A wet mount of these samples were made, using a loop tool. The wet mount was then observed with a microscope to identify the cell shapes and motility, each at different magnifications.
Gram Staining Procedure:
- the 3 samples that were collected before for the wet mount were gram stained, and the gram stained organisms were identified using a key given.
1. Slides labeled and area with smear circled with red pencil
2. Air dried slide passed through flame three times with bacterial smear side up.
3. Smear covered with Crystal Violet for 1 minute, rinsing the stain off with water after the 1 minute.
4. Smear then covered with Gram's iodine for 1 minute, again rinsing with water after the minute.
5. Decolorization done by flooding smear with 95% alcohol for 10-20 seconds, rinsing with water afterwards. When solvent flows colorlessly, slide is decolorized.
6. Safranin stain on slide for 20-30 seconds, rinsing gently afterwards.
7. Blot slide carefully with paper towels and air dry slide.
PCR:
- Of the 3 samples, 2 were chosen to be used for PCR, one from nutrient agar and one from the nutrient-tetracycline agar. Each colony was transferred to 100µL of water that was in a sterile tube, then incubated at 100°C for 10 minutes. The incubated tube was then centrifuged and 5µL of the supernatant in the tube was used for the PCR reaction.
(4)Observations and Data:
Hay Infusion Culture: Description: Hay Infusion has less water and is more settled than last weeek. Also less milky and darker in color than before. Smell is less sour, smelling more watery than sewage.
- Plates without Tetracyline are teeming with colonies, decreasing in number as there are more dilutions. - From Left to Right: 〖10〗^(-3)〖10〗^(-5)〖10〗^(-7)〖10〗^(-9)
- Sample #1. Taken from the 〖10〗^(-5) plate with no tetracycline.
- Sample #2: Taken from 〖10〗^(-5)plate with no tetracycline.
- Plates with Tetracycline show little or no colony. Fungi can be seen. - From Left to Right: 〖10〗^(-3)〖10〗^(-5)〖10〗^(-7)
- Sample #3: Taken from 〖10〗^(-3) plate with Tetracycline.
- Table of Cell morphology seen. All cells show no motility.
(5)Conclusions: The hypothesis of last week was proved correct because the agar plates with tetracycline did show less growth than those without. Compared to last week's Hay Infusion Culture, the appearence and smell of the culture changed, possibly because of evaporation. The water is not moving or disturbed in anyway, which allows for settling and the water evaporates under heat, which accounts for the loss of water.
Compared to the nutrient agar plates with tetracycline, the nutrient agar plates without tetracycline showed more growth, only showing the same level of growth as the tetracyline plate when the dilution became bigger. Those with tetracycline showed little or no growth at all, which indicates that the antibiotic prohibited growth of bacteria. Only the tetracycline plate with the least amount of dilution allowed growth, which occured because there were more bacteria or fungi than the antibiotic was able to block growth. Thus the 〖10〗^(-3) plate with tetracycline plate can be seen with fungi and bacteria colonies. Some species of bacteria that are unaffected by tetracycline are Brucella species,Escherichia coli,Klebsiella species,Shigella species,Acinetobacter species,Bacteroides species,and the Enterococcus group.Tetracycline resistance occurs in pathogenic, opportunistic, and commensal bacteria. This resistance is gained by mutation, so bacteria with this mutation would be resistant to tetracycline, which would be the colony growth seen in the 〖10〗^(-3) plate with tetracycline. Of these agar plates, it was unlikely to find archea growing on them because a majority of the archea are extermophiles, living in extreme conditions.
The tetracyclie itself inhibits protein synthesis by disallowing attachment of aminoacyl-tRNA to the ribosomal acceptor (A) site. Types of bacteria that can be treated by tetracycline are similiar to those that are resistant to tetracycline. Some of the species listed in the paragraph before can be treated with tetracycline, it's just that they can also be resistant.
Because there was a mistake made in preparing PCR, next time this would be done differently. Instead of pipetting 46µL, 23µL was pipetted. This could cause a problem in DNA sequecing for next lab. It would also be better next time to use different slides for the samples. For this lab, two colonies from the same plate were used so next time it would be better to use colonies from different slides to see what the difference in the organisms would be.
For the future, plantae and fungi from the niche woud be observed.
JS
February 09,2014 Identifying and Understanding of Algae and Protist through a Dichotomous Key
(1)Introduction: algae and protists in different regions of the Hay Infusion from Lab 1 will be analyzed using a dichotomous key. Hay Infusion will also be used to make serial dilutions, each dilution being smeared on nutrient agar plates and nutrient agar plates with tetracycline, an antibiotic. I hypothesize that the nutrient agar plates with tetracycline will show less growth and that the samples of differnt niches of the Hay Infusion will contain similiar organisms.
(2)Purpose: to understand how to use a dichotomous key, using it to identify algae and protists found in individual Hay Infusion, noting their individual characteristics. Making of Hay Infusion culture serial dilutions and smearing of agar plates with and without tetracycline to use for next lab, learning serial dilution method and agar plate smearing.
(3)Materials and Methods:
- observation of Hay Infusion culture made in last lab. Characteristics such as smell and appearence noted. 3 samples from different layers (Top (mold area),Middle (Near Plant),Bottom(near the dirt))taken to oberve organisms inside. Drop of each sample placed on a slide and observed in a microscope. 2 different organisms observed and recorded, totaling in 6 samples, 2 from each sample.
- serial dilution of Hay Infusion culture conducted for next lab. 4 tubes with clean 10 mL broth each are labled: 2,4,6,8. 100 µL from swirled Hay Infusion culture added to tube labled 2. 100 µL then taken from swirled tube 2 and transferred to tube 4. Process repeated until tube 8.
- 100 µL from each tube placed aseptically on surface of nutrient agar that corresponds to tube label. Same for nutrient agar with tetracycline.
(4)Observations and Data:
Hay Infusion Culture:
Overall, the culture is yellow/brown in color, with a sour smell.
The top layer of the Infusion has mold on top, with some plant leaves floating in between. Overall color from top is brown, riddled with some green plants.
Middle layer clear compared to top and bottom layer. Roots of plant can be seen.
Bottom layer lined with dirt and decomposed deaf leaf, mostly solid matters with high density.
Sample #1:
Colpidium sp(protist):
- clear - slow, jerkey movement - 7µm x 10 = 70µm
Gonium(algae):
- green - immobile - 3µm x 10 = 30µm
Sample #2:
Blepharisma sp(protist):
- yellowish - fast - oval - cillia - 5µm x 10 = 50µm
Colpidium sp(protist):
- white/clear - oval/circular - motile, jerkey
Sample #3:
Gonium(algae):
- green - colony - round - 15µm x 2.5 = 12.5µm
Colpidium sp(protist):
- clear - fast - circular - 6.5µm x 65µm
(5)Conclusion: Overall, the Hay Infusion gained the appearence it has currently because of the force of gravity and evaporation. Materials in the hay infusion culture were seperated according to their density and the water in the culture was evaporated into the air. Because the culture was not disturbed in any way, the materials and the water started decomposing due to inactivity, creating the sour smell. If the hay infusion culture had been observed for another two months, I would predict that more water would have evaporated and that the sour smell would have become stronger.
Colpidium sp meets the needs of life (energy, reproduction, cell, evolution, information) because it gains energy through consumption of materials in its surroundings. The energy gained from this consumption allows for reproduction. The unicellular cell is flat with a cytostome, nucleus, and a vacuole. It self-replicates, fulfilling reproduction and because of this they are able to evolve, which resulted in their current appearence, granting them cilliarly hair to move around with. Through these hairs, they are also able to gather information about their surroundings.
Part of my hypothesis was correct; Based on the data, colpidium sp and gonium were present in all 3 niches of the Hay Infusion culture. However, there were differences that resulted from the fact that the 3 samples were all taken from different areas. Sample #1 and #2, which was taken near the plant exhibited a lot of cell movement and a lot of organims compared to sample #3. This result would be because of the fact that the organisms feed on the plant matter. The lack of plant matter in the bottom of the hay infusion culture meant a lack of food for the organisms, making organisms to be scarce or dead. On the other hand, sample #1 and #2 with their abudant algae and plant growth created a perfect enviroment for the organsism insdie the culture. The hypothesis on the growth on the agar plates cannot be confirmed untill next week's lab.
This lab can perhaps be improved if the slides can be dyed because it was hard to see the organisms. Other than this, there seems to be nothing that I would do differently.
JS 2/6/14, lab 1 notes
Great job!!! Make sure you sign each entry at the bottom of each entry. Good work.
AP
January 31,2014: Understanding Natural Selection and Observing Abiotic and Biotic Characteristics of a Niche
(1)Introduction:observation of green algae of volvocine line and observation of niche and its biotic/abiotic factors I hypothesize that the Volvox would be the most advanced out of the three green algae that are to be observed.
(2)Purpose:to understand natural selection by looking at three green algae (Chlamydomonas, Gonium, Volvox) of the volvocine line in order to observe the selective functions that organisms have developed and to determine the biotic and abiotic characteristic of a niche in American University, forming a hay infusion at the end in order to determine organisms that exist in niche.
(3)Materials and Methods:
- observation of three types green algae, Chlamydomonas, Gonium, Volvox of the volvocine line. Each placed upon slide and observed through a microscope. Number of cells observed, Colony Size, Functional Specialization of Cell, and Reproductive Specilization (whether the cell is isogamy or oogamy) of the cell were recorded.
- journey outside in different groups to observe specific niche in American University. Topography, biotic/abiotic features of niche, Location, and specific informations about niche were observed and recorded. Samples of the niche were collected to use for hay infusion for next lab.
(4)Observations and Data:
Chlamydomonas:
- 1 observed cell with colony size of 25. - single celled - egg-shaped cells that are easily visible - cup shaped chloroplast with pyrenoid - flagella for motility - Isogamy
Gonium:
- 5 observed cell with coloy size of 4 - colonies normally range from 4,8,16,32 cells, each able to form a new colony - Oogamy
Volvox:
- 3 cells observed with 2.5 colony size - thousands of cells that make up colony - has gametes - has anterior/posterior pole of cell - Oogamy
Niche #4:
Description:located in area across from Katzen Art Center, across Massachusetts Ave NW. Area constructed as drainage in case of snow and rain. Because of the purpose that it was built for, niche laid out with rocks and pebbles. Types of vegetation that can live with excess amounts of water and that have great absorptivity such as cat tails. Mud and sand rather than dry dirt because of reasons mentioned before. Some grass at edge of transect. Humans and squirrels near transect.
Abiotic Factors:
- air, wind - dirt, sand, mud - sunlight - rocks,pebbles - sidewalk - moisture,water
Biotic Factors:
- plants (grass, cat tails), dead leaves - humans - squirrels - fungi (on rock) - bugs, worms
Image of Niche #4:https://drive.google.com/a/student.american.edu/file/d/0BzQOqxfdJTX9SC1iVGhIRDlPcTA/edit?usp=sharing
(5)Conclusions: Orignial purpose was fulfiled and hypothesis was proven correct. Colony size decreased from Chlamydomonas to Volvox. The data showed that natural selection chooses characteristics that would benefit the specie and that regression does not mean evolution has not occured. It all depends on what benefits the specie in total. To improve the experimental design, the lab should be divided up because for some time, people were left waiting until the others finished to continue the lab portions. Future plans would be to use the hay infusion that was made and observe the organismss such as bacterias in the infusion. The change in the hay infusion would also be recorded.
January 22, 2014- successfully added text